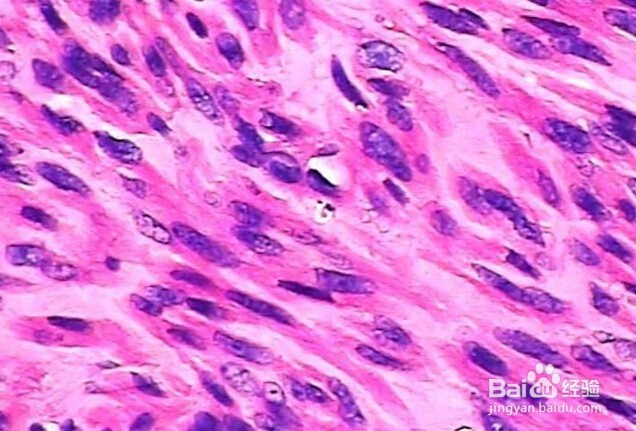
HE染色操作步骤

HE染色操作步骤
1、组织学、胚胎学、病理学教学与科研。
1、取材,固定:固定液——甲醛(福尔马林)
从人或动物新鲜尸体上取下组织块(一般厚度不超过0.5厘米)投入预先配好的固定液中(10%福尔马林,Bouin氏固定液等)使组织、细胞的蛋白质变性凝固,以防止细胞死后的自溶或细菌的分解,从而保持细胞本来的形态结构。
2、修剪,脱水,透明:脱水剂——酒精
透明剂——二甲苯
不同组织固定时间不同,固定成功后需要修剪25px*25px*5px,放入包埋盒中,流水冲洗(去除组织中的固定液)30分钟。至于不同浓度的酒精脱水,一般用由低浓度到高浓度酒精作脱水剂,逐渐脱去组织块中的水份。再将组织块置于既溶于酒精,又溶于石蜡的透明剂二甲苯中透明,以二甲苯替换出组织块的中酒精,才能浸蜡包埋。
3、浸蜡,包埋:石蜡
将已透明的组织块置于已溶化的石蜡中,放入溶蜡箱保温。待石蜡完全浸入组织块后进行包埋,冷却凝固成块即成。包埋好的组织块变硬,才能在切片机上切成很薄的切片。
4、切片、展片、烤片:
将包埋好的蜡块固定于切片机上,切成薄片,一般为5—8微米厚。切下的薄片往往皱折,要放到加热的水中烫平,再贴到载玻片上,放45℃恒温箱中烘干。
5、脱蜡、至水、染色:脱蜡剂:二甲苯
至水剂:酒精
染色剂:苏木精水溶液,酒精伊红染
1、 染色前,须用二甲苯脱去切片中的石蜡,再经由高浓度到低浓度酒精,最后入蒸馏水,就可染色。
苏木精(Hematoxylin,H)是一种碱性染料,可将细胞核和细胞内核糖体染成蓝紫色,被碱性染料染色的结构具有嗜碱性。伊红(Eosin,E)是一种酸性染料,能将细胞质染成红色或淡红色,被酸性染料染色的结构具有嗜酸性。
1、将已入蒸馏水后的切片放入苏木精水溶液中染色数分钟。
2、酸水及氨水中分色,各数秒钟。
3、流水冲洗1小时后入蒸馏水片刻。
4、入70%和90%酒精中脱水各10分钟。
5、入酒精伊红染色液染色2—3分钟。
1、染色后的切片经纯酒精脱水,再经二甲苯使切片透明。
1、将已透明的切片滴上树胶,盖上盖玻片封固。待树胶略干后,贴上标笺,切片标本就可使用。
生理盐水、蒸馏水、PBS实验必备溶剂,里面的很多试剂不用亲自买,应该有专门做切片和染色的实验室吧,都是公用的哦!!